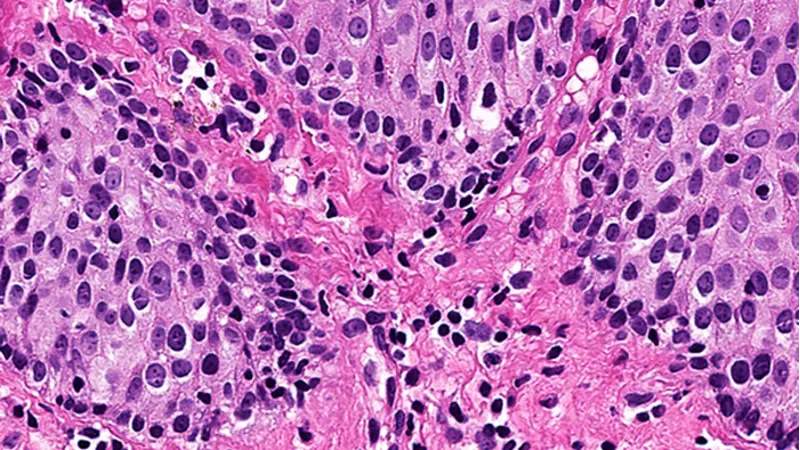
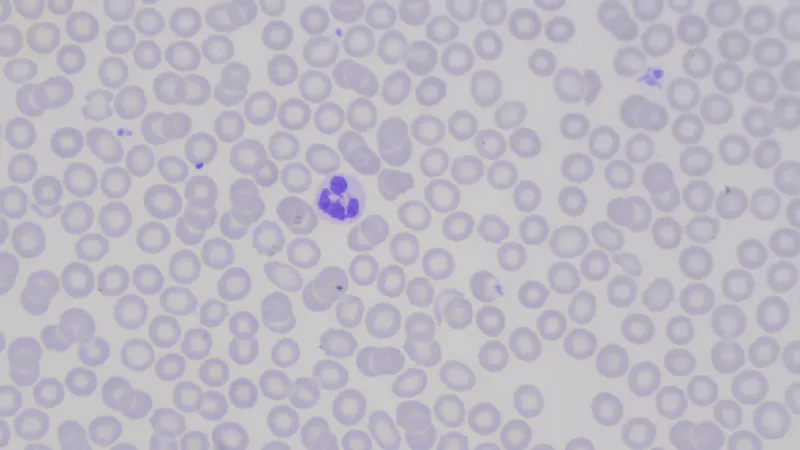
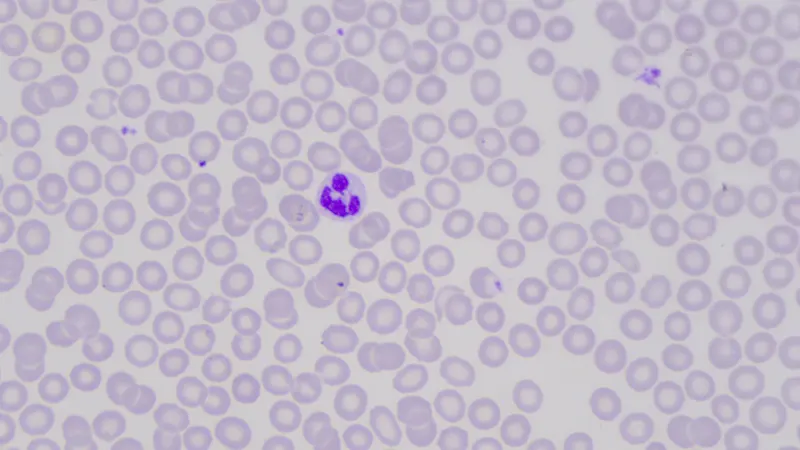

色彩完美 - 让色彩设置变得简单灵活
色彩完美 - 让色彩设置变得简单灵活
为了获得正确的色彩印象,医疗和生命科学应用需要单独的色彩设置。这是因为在显微镜和眼科等应用中,图像是构成医疗决策的基础。色彩配置往往非常复杂耗时。通过预设置和多项实用工具,“Basler MED功能包-色彩完美”功能可尽量降低您的工作难度,并同时为您提供可单独调整的空间。
>
色彩完美功能的优势
借助Basler色彩校准工具,只需点击几下鼠标即可实现卓越的色彩保真度
可通过调整色度、饱和度、亮度和对比度来控制整个色彩空间
可使用专利6轴操作器来单独调整色彩空间中的单个颜色
可选择针对不同光源的色彩预先设置
Basler色彩校准工具:让色彩校准变得易如反掌
色彩重现对于医疗和生命科学领域的图像极为重要。相机需要正确的设置才能获得出色的色彩保真度,即让真实图像和数字投影之间的色彩误差降到最低。然而,要找到"完美"的色彩设置较为复杂。pylon软件中的Basler色彩校准器为此类原本复杂的任务提供了一个简单、快速的解决方案。
适用于整个色彩空间的单独设置,可实现100%的灵活性
不同的应用需要采用不同的色彩设置。利用“MED功能包-色彩完美”功能可以设置并控制整个色彩空间。可根据个性化要求手动调整色度、饱和度、亮度和对比度。

Basler 6轴操作器:可单独设置每种颜色
有时,只需调整一种颜色,即可让图像呈现完美的色彩印象。借助Basler专有的6轴操作器能轻松解决这个问题,让您可以设置单个颜色。所有功能都在相机自身的FPGA上运行,从而为客户的主机系统节省大量资源。

省时省力:为不同的光源系统使用色彩预先设置
您是否在应用中使用标准光源?“MED功能包-色彩完美”为最常见的光源提供了经过优化的色彩预先设置。除了在工业图像处理领域中久经考验的设置外,它还集成了常见的光源设置,例如集成用于显微应用的Olympus(奥林巴斯)显微镜LED(4500 K和6000 K)或Leica(徕卡)显微镜LED (5500 K)。为光源选择色彩预先设置,为您省时省力。